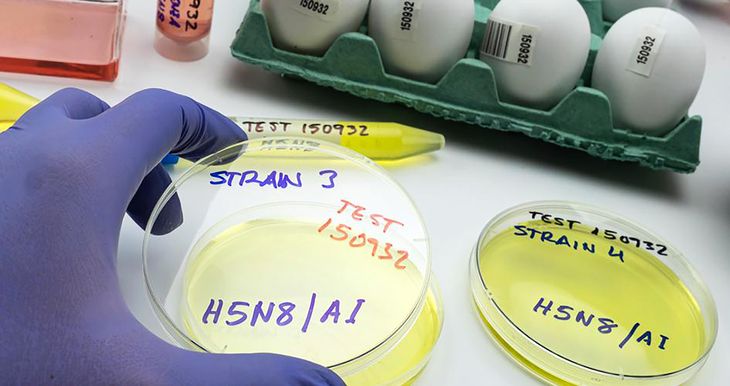
La gripe aviar en Uruguay está mayormente controlada, pero un contagio en el circuito comercial podría generar graves daños económicos.

La gripe aviar todavía no es una anécdota en Uruguay y, si bien hasta el momento solo se han registrado diez focos —ninguna al interior del circuito comercial— y ya se ha comenzado la vacunación obligatoria, la posibilidad de un brote que complique al sector avícola y a la economía nacional no está reducida a cero. En este escenario, cabe preguntarse cuál sería el impacto de la aparición del virus en una granja comercial, tanto a nivel de comercio exterior como para los productores e, incluso, los consumidores finales del mercado interno.
El virus de la Influenza Aviar llegó al país a mediados de febrero y, desde entonces, avanzó sin prisas pero sin pausas por todo el territorio nacional, alcanzando circulación en varios departamentos y al punto de ser calificada como “amenaza epidemiológica” por parte del Ministerio de Ganadería, Agricultura y Pesca (MGAP).
El principal motivo de contagio fueron las aves migratorias, razón por la cual seis de los diez focos que se registraron hasta la actualidad en el país fueron en aves autóctonas, mayormente cisnes Cuello Negro. Los otros, ocurrieron en aves de traspatio, en predios rurales de productores que utilizaban estos especímenes para el autoconsumo.
Por el momento, el impacto económico todavía no es más que una hipótesis frente al caso de que aparezcan contagios en las granjas destinadas al comercio interno y externo. “Hasta ahora venimos sin casos en el circuito comercial, Uruguay sigue manteniendo su status sanitario y se están tomando todas las medidas para mantener la situación”, explicó el director general de la Granja (Digegra) del MGAP, Nicolás Chiesa, a Ámbito.com.
Para esto, el ministerio ha destinado un presupuesto de alrededor de 4 millones de dólares, contemplando el universo de medidas implementadas para evitar el avance del virus: entre ellas, la entrega de créditos de hasta 28 mil dólares para los productores —a cinco años y sin interés, con dos años de gracia— para la inversión en bioseguridad en los establecimientos avícolas; y la compra de casi 10 millones de dosis de la vacuna contra la gripe aviar por un total de 400 mil dólares— cuya aplicación comenzó el pasado martes.
Un brote en el circuito comercial, el peor de los casos
Si bien el avance de la vacunación en las granjas comerciales reducen la posibilidad de un contagio en el sector productivo y las medidas de bioseguridad están orientadas a evitar el contacto con aves silvestres que puedan transportar el virus, todavía quedan restos de temor tanto en las autoridades como en los productores.
No es exagerado: tal y como señaló Federico Stanham, director ejecutivo de la Cámara Uruguaya de Procesadores Avícolas (Cupra), a Ámbito.com, “el impacto sería muy importante para todo el sector”.
“En cada granja comercial que se detecte el virus será necesario sacrificar todo el lote, perjudicando a las plantas de faena que son las dueñas de las aves y a los productores que prestan el servicio de engorde de manera tercerizada”, explicó el ingeniero agrónomo. “Si la detección ocurre en las granjas donde las plantas de faena crían las reproductoras, el daño es exponencial ya que se corta la vida del lote de madres que dejará de dar la producción esperada por varios meses hacia adelante”, añadió.
Al respecto, Chiesa también señaló el tiempo de parada que tendrían las diferentes granjas, entre la pérdida de animales por el sacrificio sanitario y los procesos de desinfección que deberían llevarse a cabo. “Hoy tener una gallina en producción te lleva entre seis y siete meses, por lo que si el virus ingresa a una granja productora de huevos, fácilmente podrías tener un año sin actividad”, consideró el titular de la Digegra.
Este sería el daño directo a los productores, pero también tendría su correlato a nivel de mercado interno y en los precios para los consumidores finales. Si bien dependería, en un primer lugar, de la etapa de la cadena en la cual ocurra el brote y cuántas granjas fueran afectadas, una menor oferta influiría directamente en el valor de los productos.
Un ejemplo es el de los huevos, tal y como sucedió en Brasil con la detección de los primeros casos en la región —si bien este país no registró focos de gripe aviar— o en Estados Unidos, a mediados del 2022: si las gallinas ponedoras fueran afectadas y, como señaló Chiesa, las granjas tuvieran que estar sin trabajar por largos períodos de tiempo, el precio de este producto aumentaría frente a la escasez. En el país nortemericano, el valor de los huevos aumentó en un 70% interanual en enero, la suba más pronunciada en cuatro décadas, debido al grave brote de Influenza Aviar. Lo mismo sucedería con otros productos de la cadena avícola, que deberían ser suplementados con importación.
Otro costo del impacto de un posible brote sería la pérdida del status sanitario del país, lo que complicaría la colocación de subproductos avícolas en los mercados internacionales. Lo cierto es que Uruguay exporta apenas un 10% de su producción aviar, un porcentaje que en 2021 supuso un monto de 1 millón de dólares en ingresos, según los datos oficiales de Uruguay XXI —en 2022, esta cifra pudo verse incrementada por el comienzo de exportaciones hacia Baréin. Pero también se verían afectadas las negociaciones en medio de los esfuerzos del MGAP por abrir las puertas de nuevos mercados para los productos avícolas uruguayos, como es el caso de China.
huevos-maple.jpg
El aumento en el precio de los huevos podría ser una de las primeras consecuencias de un brote de gripe aviar en Uruguay.
Más conocimiento para mayor prevención
Una buena parte del sector avícola rescata la velocidad y atino con la que actuó el MGAP frente a la aparición de la gripe aviar en el país. Así lo señala Stanham al considerar que la cartera “realiza un muy buen trabajo de detección temprana de brotes y gestión de los focos para limitar al máximo la diseminación del virus”; y así también los destacaron desde la Asociación de Productores Avícolas Sur (APAS), que nuclea a productores de huevos en Uruguay.
En este contexto, la solicitud de crear un Grupo Asesor Científico Honorífico (GACH) sobre gripe aviar por parte de Cupra fue entendida como un indicador de malestar por parte de los productores avícolas y de reclamo por mayores medidas al respecto. Sin embargo, “lo que buscamos es el involucramiento y no necesariamente honorario de la comunidad científica a través de la ANII, con el objetivo de enriquecer el conocimiento y seguir la evolución de la epidemia en todas sus dimensiones, no solo la de sanidad animal, asesorando a los actores públicos y privados”, explicó Stanham.
El objetivo del GACH fue tratar de replicar la experiencia positiva de esta dinámica frente a la pandemia de Covid-19. “De esta forma se puede hacer un aporte al muy buen trabajo que realizan los técnicos del MGAP, sumando al esfuerzo que significa gestionar un tema totalmente nuevo para el país y que tendrá un dinamismo de conocimiento muy importante en los próximos meses y años”, señaló el director ejecutivo de Cupra.
Tanto para Stanham en particular, como para el sector avícola en general, “es clave contar con un amplio respaldo científico para poder preservar el trabajo que el sector viene realizando para mejorar la competitividad, la calidad y la eficiencia del proceso productivo, incorporando tecnología y valor agregado y en especial de cara al proyecto exportador del rubro para acceder a mercados de alta exigencia”. El reclamo pendiente es que la avicultura no ha recibido atención sistemática de la ciencia desde hace mucho tiempo.
La situación de la vacunación obligatoria es un debate en este sentido que todavía no está saldado, debido a las implicancias que supone la inoculación. “Hoy la vacunación y la presencia de la enfermedad son una barrera para el acceso a nuevos mercados de exportación y es necesario considerar las implicancias de esto en el proyecto de desarrollo que el sector ha planteado al gobierno”, señaló el director ejecutivo de Cupra, dando cuenta del dilema al que se enfrenta el sector, en el cual el gobierno, por el momento, priorizó la contención del virus por fuera del circuito productivo.
“Sostenemos que es necesario acompañar la decisión de la vacunación con otras medidas complementarias, para no poner en riesgo el proyecto de modernización del rubro, sus expectativas de exportación ni generar situaciones ambiguas a los productores”, concluyó Stanham.